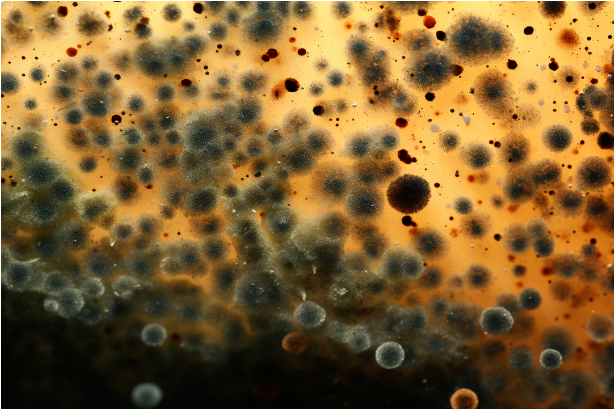

相關附件:
又到了
廣東人熟悉的濕熱天氣
不僅室外濕、室內潮
連車里都是“焗焗的”

有車一族、打車一族
如果最近坐車開空調
漸漸發覺
“車里有股酸臭味”
“一開空調就鼻子癢”
……

很大可能是
車載空調發霉了!
吹出來的風
都是被霉菌污染的氣流......

霉菌是真菌的一種,真菌在環境中的適宜生存條件是:空氣濕潤、溫暖、陰暗。
真菌生長繁殖能力很強,只要氣候條件合適,即使只有極少量的營養物也能生長。
當真菌孢子附著在有營養源的地方(如空調部件和管路中的塵埃、液沫小滴、飛沫等),在溫度20~35℃、相對濕度70%~100%時,就會大量生長繁殖。 菌絲逐漸伸長,數日生長成熟,產生孢子,成熟的孢子又會釋放出來污染空氣。

需要注意的是,這些小孢子常被視為過敏人群的“隱形殺手”。
大家吹空調時流鼻涕并不一定是著涼,很可能是空調里潛伏的霉菌孢子讓鼻子過敏了,空調很可能是霉菌的“大本營”。

1. 車內的空調在運行過程中,空調吹出冷風導致與車外出現溫差,空調蒸發器上出現冷凝水。

2. 車外空氣濕度大時,空氣中的水分進入空調風道內,與附著在蒸發箱及風管內壁的塵埃相結合。

3. 下雨天人進車內,腳墊受潮,車內環境長時間在22~35℃、相對濕度80%時,霉菌孢子便快速生長,大量繁殖,長出霉菌。
4. 長期不使用的車輛,也容易滋生霉菌。

1. 吹干水蒸氣 在汽車使用空調制冷的狀態下,建議提前5分鐘關閉制冷模式,開啟自然通風模式,利用自然風吹干風管和冷卻器上的水蒸氣。也可在停車后,開啟熱風吹2分鐘,烘干水氣。

2. 保持車內整潔衛生 應注意車內的整潔衛生,保持腳墊干燥,盡可能減少霉菌的生存空間。 3. 定期清洗車載空調 長期擱置的空調容易滋生霉菌,影響車內空氣質量。

必須摒棄“空調不臟不清洗”的錯誤觀念!車載空調一定要記得定期清洗!
來源:健康廣東